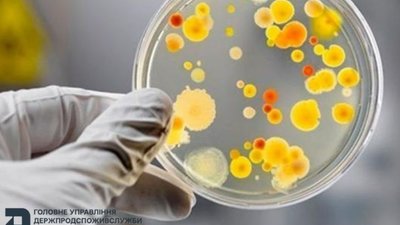
Зросла кількість постраждалих від спалаху кишкової інфекції у відпочинковому таборі на Львівщині (ВІДЕО)

На Закарпатті поліція знайшла власницю собак, які нападали на людей
Правоохоронці розпочали перевірку та знайшли жінку, якій належать тварини

Правоохоронці розпочали перевірку та знайшли жінку, якій належать тварини

Коаліція також закликала РФ надати повну й підтверджену інформацію про місцеперебування, стан і правовий статус усіх дітей

Відтак усі власники й співвласники квартир отримають компенсацію на нове житло

За попередніми даними, у квартирі вибухнув газовий балон

До війська надійшли зразки нової оптики, засобів зв’язку, автомобілів і бронетехніки

Зараз 40% від усіх відстрочок оформлюється саме в застосунку Резерв+

Санкційні обмеження будуть задіяні вже наприкінці тижня

На вулиці Трускавецькій зіткнулися легковик та мотоцикліст, за попередніми даними мотоцикліст - курєр Глово

Прощання та чин похорону захисника розпочнеться о 12:00 у Гарнізонному храмі свв. апп. Петра і Павла у Львові

В організатора вилучили 5 мобільних телефонів, автомобіль, банківські картки та чорнові записи, що використовувалися для координації незаконної діяльності

Жінці загрожує до 10 років позбавлення волі з конфіскацією майна

Встановлюють місцеперебування Биха Бориса Броніславовича, 1970 року народження

До нової системи потраплять дані з ЕСОЗ, реєстрів ТЗ та нерухомості, перетину кордону та сплати податків

Станом на 6 серпня 2025 року жінку знайдено! Всім дякуємо!

Найбільше бійців стали до строю у ЗСУ, також активно військові повертались до НГУ та ДПСУ

Чоловік пішов з дому 26 липня і не повернувся, зв'язку з ним немає

Травмовану дитину керманич легковика негайно відвіз до лікарні

На тлі заяв президента США, світові ціни на "чорне золото" продовжують знижуватися

80 відсотків цьогорічних вступників на аспірантуру — чоловіки
З первинним діагнозом «гостра кишкова інфекція» вже госпіталізовано 32 особи

Роботи відбуватимуться на 34 ділянках, які забезпечують важливі сполучення для велосипедного руху

Мешканці вже отримали відповідні повідомлення від КП «Теплокомуненерго»

На Харківщині загинув Ігор Климович, молодший лейтенант Третьої окремої штурмової бригади Сухопутних військ ЗСУ

Українських водіїв почали розвертати на кордоні з Румунією — без техогляду не пропускають

Намагався знищити релейні шафи сигнальних установок на залізничному сполучені прикордонного регіону

Зрадник коригував ракетно-дронові атаки росіян по Києву

З’явився коментар поліції та єпархії УПЦ МП

На дорогах області за останню добу сталося 10 ДТП з потерпілими

У разі отримання будь якої інформації просимо повідомити за телефонами 0675897707 або 0967551809

Станом на 5 серпня 2025 року на 17 годину жінку знайдено - жива!

Чоловіка зупинили на вулиці з метою перевірки облікових даних

Від отриманих травм дівчинка загинула на місці події

Внаслідок ДТП у Новому Роздолі травмована неповнолітня пасажирка мотоцикла

У Дрогобичі відбулося зіткнення мікроавтобуса та автомобіля Opel Zafira

Шестеро цивільних осіб поводилися агресивно та вимагали передати військовозобов’язаного їм

Директор компанії впродовж кількох років не сплачував єдиний соціальний внесок на загальнообов’язкове державне соціальне страхування

Петр Павел також зазначив, що Захід не хоче знищення української нації

Станом на ранок 5 серпня, до лікарень госпіталізували понад 20 дітей

Життя Захисника обірвалося 29 листопада 2024 року поблизу н.п. Веселий Гой, Донецької області

Ультиматум Трампа, який він висунув Путіну щодо мирної угоди, закінчується пізніше цього тижня